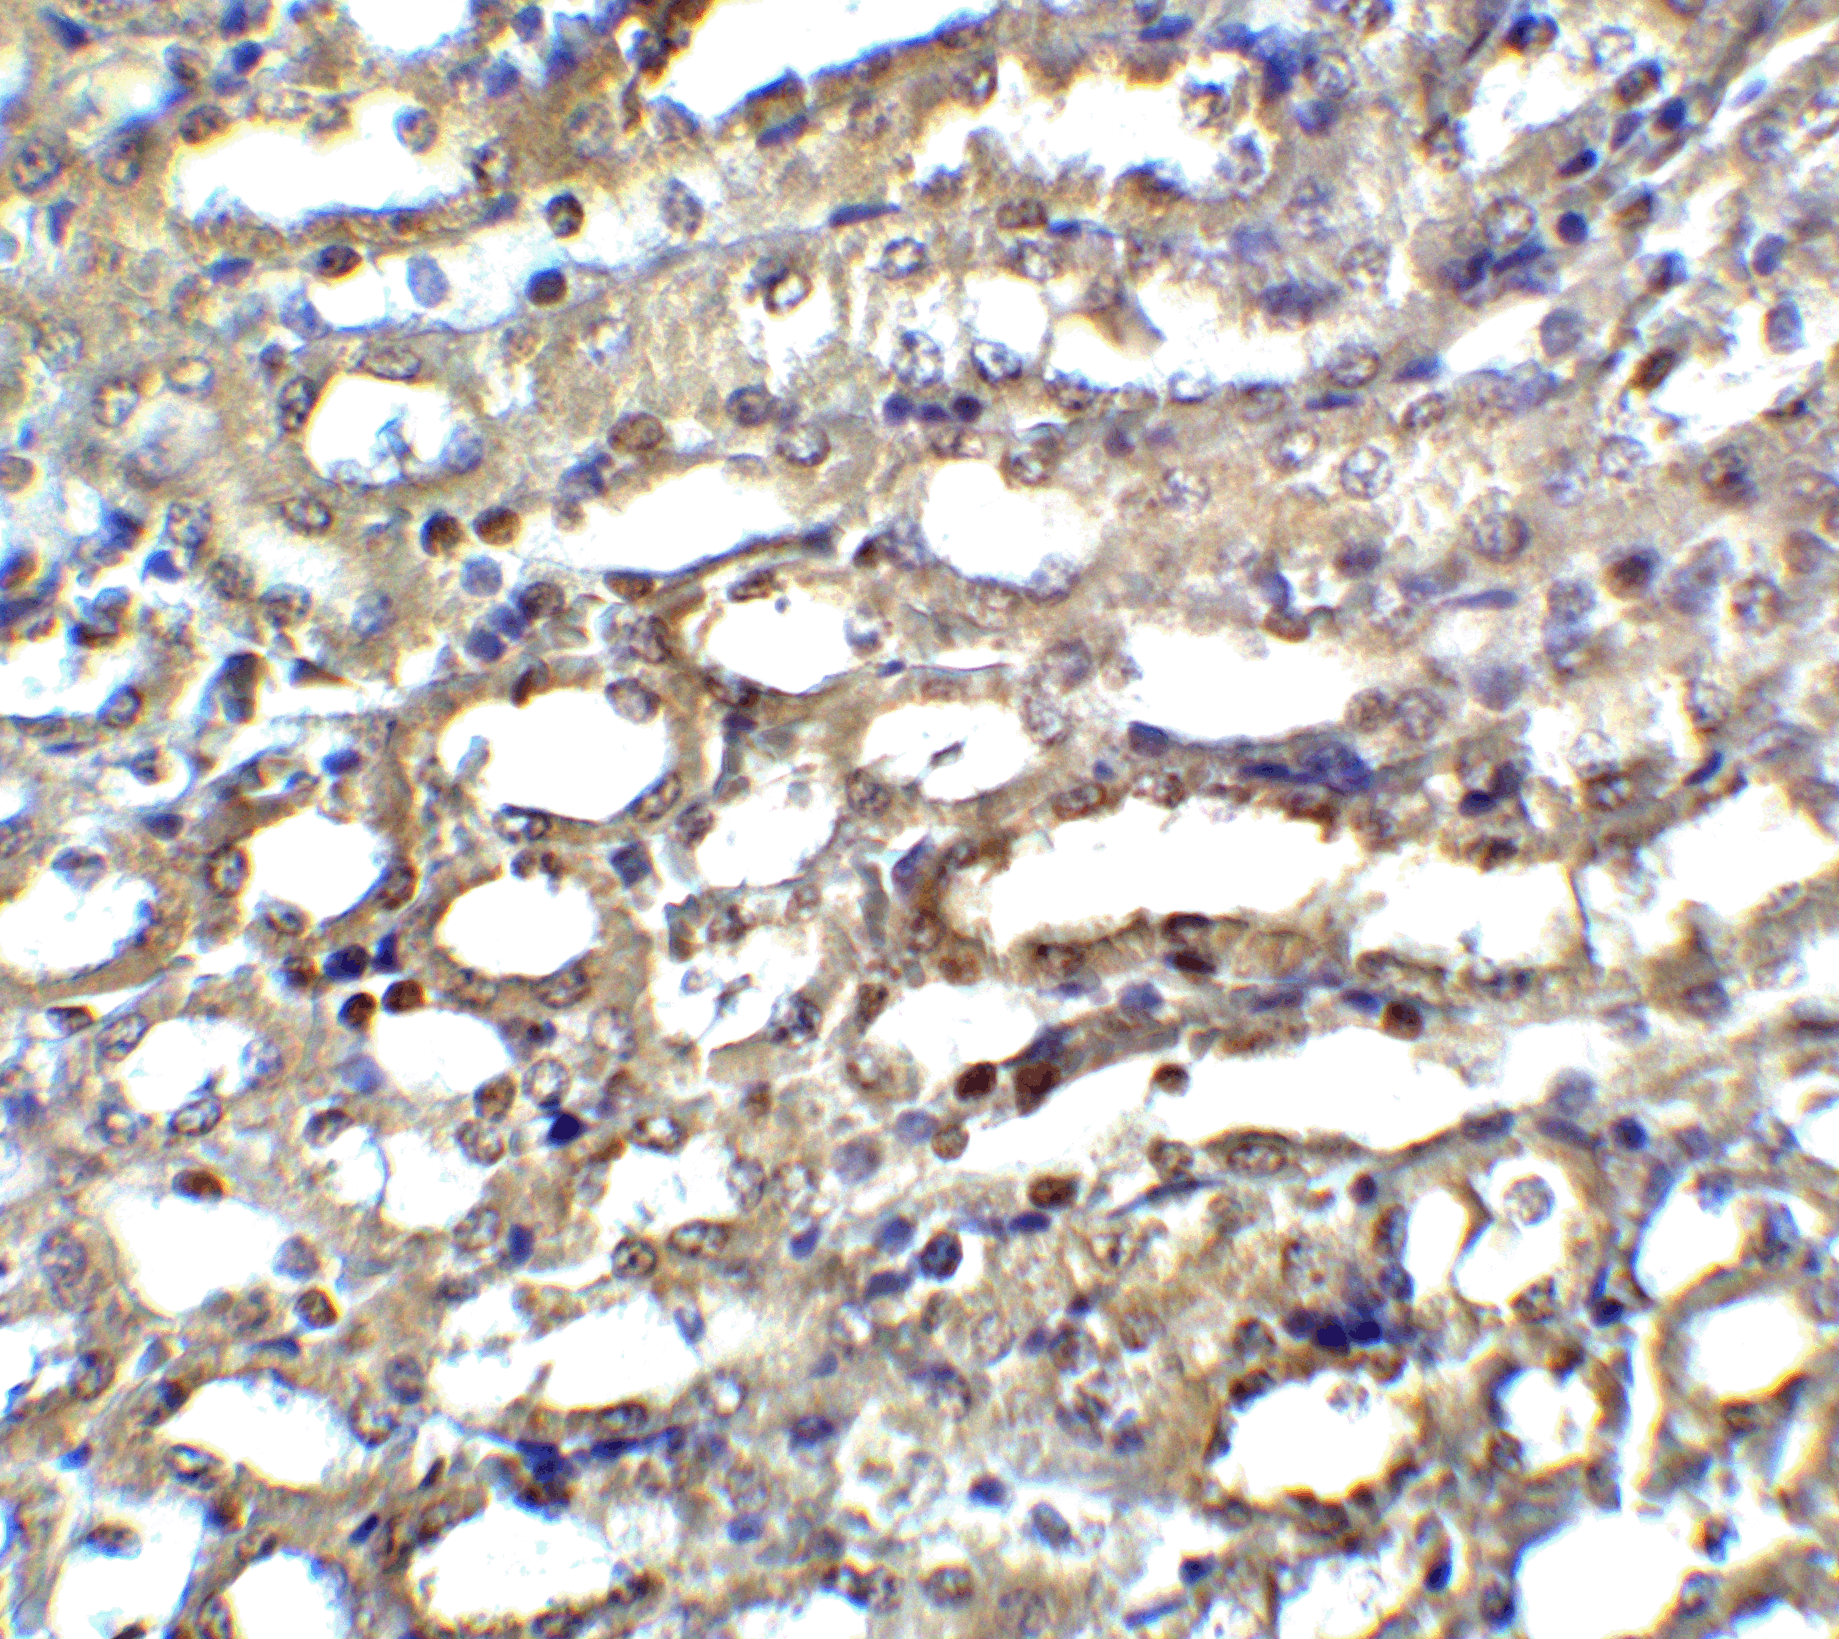
Immunohistochemistry of ICAD in mouse kidney tissue with ICAD antibody at 5 μg/ml. Immunohistochemistry of ICAD in mouse kidney tissue with ICAD antibody at 5 μg/ml.

ICAD Antibody
Product Code:
PSI-2003
PSI-2003
Host Type:
Rabbit
Rabbit
Antibody Isotype:
IgG
IgG
Antibody Clonality:
Polyclonal
Polyclonal
Regulatory Status:
RUO
RUO
Applications:
- Enzyme-Linked Immunosorbent Assay (ELISA)
- Western Blot (WB)
No additional charges, what you see is what you pay! *
| Code | Size | Price |
|---|
| PSI-2003-0.02mg | 0.02mg | £150.00 |
Quantity:
| PSI-2003-0.1mg | 0.1mg | £453.00 |
Quantity:
Prices exclude any Taxes / VAT
Stay in control of your spending. These prices have no additional charges to UK mainland customers, not even shipping!
* Rare exceptions are clearly labelled (only 0.14% of items!).
* Rare exceptions are clearly labelled (only 0.14% of items!).
Multibuy discounts available! Contact us to find what you can save.
This product comes from: United States.
Typical lead time: 14-21 working days.
Contact us for more accurate information.
Typical lead time: 14-21 working days.
Contact us for more accurate information.
- Further Information
- Documents
- Related Products
- Show All
Further Information
Additional Names:
ICAD Antibody: ICAD, DFF35, Dff45, ICAD-L, ICAD-S, A330085O09Rik, Icad, DNA fragmentation factor subunit alpha, DNA fragmentation factor 45 kDa subunit, DFF-45
Application Note:
ICAD antibody can be used for detection of of ICAD by Western blot at 1:1000 dilution. A 45 kDa band can be detected. Antibody can also be used for immunohistochemistry starting at 5 μg/mL. For immunofluorescence start at 5 μg/mL.
Antibody validated: Western Blot in mouse samples; Immunohistochemistry in mouse samples and Immunofluorescence in mouse samples. All other applications and species not yet tested.
Antibody validated: Western Blot in mouse samples; Immunohistochemistry in mouse samples and Immunofluorescence in mouse samples. All other applications and species not yet tested.
Background:
ICAD Antibody: Apoptosis is related to many diseases and induced by a family of cell death receptors and their ligands. Cell death signals are transduced by death domain containing adapter molecules and members of the caspase family of proteases. These death signals finally cause the degradation of chromosomal DNA by activated DNase. A human DNA fragmentation factor (DFF) was identified recently which was cleaved by caspase-3 during apoptosis. Mouse homologue of human DFF was identified as a DNase inhibitor designated ICAD, for inhibitor of caspase-activated DNase. Upon cleavage of DFF/ICAD, a caspase activated deoxyribonuclease (CAD) is released and activated and eventually causes the degradation of DNA in the nuclei. Therefore, the cleavage of CAD inhibitor molecule DFF/ICAD, which causes DNase activation and DNA degradation, is the hallmark of apoptotic cell death.
Background References:
- Liu X, Zou H, Slaughter C, Wang X. DFF, a heterodimeric protein that functions downstream of caspase-3 to trigger DNA fragmentation during apoptosis. Cell 1997;89:175-184
- Enari M, Sakahira H, Yokoyama H, Okawa K, Iwamatsu A, Nagata S. A caspase-activated DNase that degrades DNA during apoptosis, and its inhibitor ICAD. Nature 1998;391:43-50
- Sakahira H, Enari M, Nagata S. Cleavage of CAD inhibitor in CAD activation and DNA degradation during apoptosis. Nature 1998;391:96-99
- Wyllie A. Apoptosis. An endonuclease at last. Nature 1998;39120-21 (RD1299)
Buffer:
ICAD Antibody is supplied in PBS containing 0.02% sodium azide.
Concentration:
1 mg/ml
Conjugate:
Unconjugated
DISCLAIMER:
Optimal dilutions/concentrations should be determined by the end user. The information provided is a guideline for product use. This product is for research use only.
Immunogen:
ICAD antibody was raised against a 20 amino acid peptide near the carboxy terminus of mouse ICAD.
The immunogen is located within the last 50 amino acids of ICAD.
The immunogen is located within the last 50 amino acids of ICAD.
NCBI Gene ID #:
13347
NCBI Official Name:
DNA fragmentation factor, alpha subunit
NCBI Official Symbol:
Dffa
NCBI Organism:
Mus musculus
Physical State:
Liquid
PREDICTED MOLECULAR WEIGHT:
45 kDa
Protein Accession #:
O54786
Protein GI Number:
9087146
Purification:
ICAD Antibody is affinity chromatography purified via peptide column.
Research Area:
Apoptosis
Swissprot #:
O54786
User NOte:
Optimal dilutions for each application to be determined by the researcher.
Documents
Related Products
| Product Name | Product Code | Supplier | ICAD Peptide | PSI-2003P | ProSci | Summary Details | |||||||||||||||||||||||||||||||||||||||||||||||||||||||||||||||||||||||||||||||||||||||||||||
|---|---|---|---|---|---|---|---|---|---|---|---|---|---|---|---|---|---|---|---|---|---|---|---|---|---|---|---|---|---|---|---|---|---|---|---|---|---|---|---|---|---|---|---|---|---|---|---|---|---|---|---|---|---|---|---|---|---|---|---|---|---|---|---|---|---|---|---|---|---|---|---|---|---|---|---|---|---|---|---|---|---|---|---|---|---|---|---|---|---|---|---|---|---|---|---|---|---|---|---|